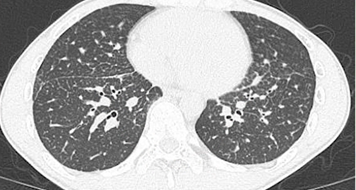

- 2025年10月14日
肺紋理(肺の血管や気管支が分岐して網目状に見える模様)がしっかり確認できる胸部レントゲン(X-p)写真
肺紋理がしっかり見えるということは、肺血管の肥大、気管支炎の炎症などが考えられます。合わせてどのような所見があるかも非常に重要になります。

このレントゲン写真では肺紋理がしっかり確認できることに加え肺門部リンパ節が確認できます。このような場合、サルコイドーシス、リンパ腫、リンパ増殖性疾患、癌性リンパ管症を鑑別に挙げます。
CTにて精査に進みます。
CTでは粒状影が多発しています。気管支鏡検査(TBLB)施行し、サルコイドーシスの確定診断です。鑑別にサルコイドーシスを挙げていると、あらかじめACEやリゾチームなどを出せるようになります。
柏五味歯科内科リウマチクリニック
ホームページ